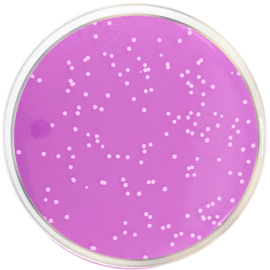
main product photo

Close
ROSE BENGAL AGAR + DICHLORAN + CLORAMPHENICOL (DRBC AGAR) 500 grams/bottle
SKU
CDL/1160
Brand
CONDALAB
Pre-order (Deliver in 8 to 12 weeks)
Rose Bengal Agar + Cholamphenicol + Dichloran (DRBC Agar) is a selective medium recommended by ISO 21527-1 for the enumeration of yeasts and molds, by means of the colony count technique, in foods products for human consumption and animals feeding stuffs which have a water activity greater than 0,95, such as meat, eggs, dairy products (except milk powder), fruits, fresh pastes, vegetables, etc. This formula is a modification of Rose Bengal Agar.
Peptone provides the nitrogen, vitamins, minerals and amino acids source. Dextrose is the fermentable carbohydrate as a carbon and energy source. Potassium phosphate is the buffer. Magnesium sulfate provides sulfur and other trace elements. Rose bengal is a selective agent that inhibits the growth of bacteria and limits the size and height of faster-growing molds, allowing for the development and detection of other slower-growing yeasts. Molds appear pink colored. Chloramphenicol serves as a selective agent, inhibiting bacterial growth. It is a recommended antibiotic for neutral media due to its heat stability and wide bacterial spectrum. The addition of dichloran prevents the fast spreading of mucoraceous fungi and also restricts the size of the colonies of other genera, improving the colony count. Bacteriological agar is the solidifying agent.
Rose Bengal Agar + Cholamphenicol + Dichloran (DRBC Agar) is a selective medium recommended by ISO 21527-1 for the enumeration of yeasts and molds, by means of the colony count technique, in foods products for human consumption and animals feeding stuffs which have a water activity greater than 0,95, such as meat, eggs, dairy products (except milk powder), fruits, fresh pastes, vegetables, etc. This formula is a modification of Rose Bengal Agar.
Peptone provides the nitrogen, vitamins, minerals and amino acids source. Dextrose is the fermentable carbohydrate as a carbon and energy source. Potassium phosphate is the buffer. Magnesium sulfate provides sulfur and other trace elements. Rose bengal is a selective agent that inhibits the growth of bacteria and limits the size and height of faster-growing molds, allowing for the development and detection of other slower-growing yeasts. Molds appear pink colored. Chloramphenicol serves as a selective agent, inhibiting bacterial growth. It is a recommended antibiotic for neutral media due to its heat stability and wide bacterial spectrum. The addition of dichloran prevents the fast spreading of mucoraceous fungi and also restricts the size of the colonies of other genera, improving the colony count. Bacteriological agar is the solidifying agent.
| Brand | CONDALAB |
|---|
Write Your Own Review

Validate your login